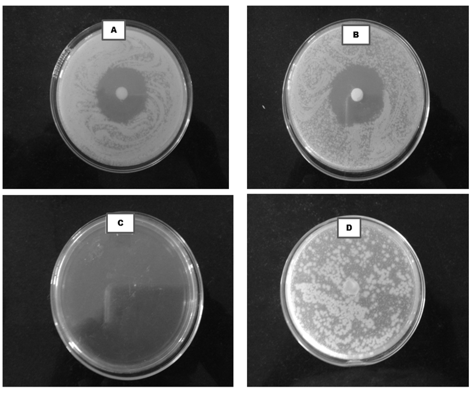

Int J App Pharm, Vol 8, Issue 4, 2016, 53-59Original Article
ENHANCED DERMAL DELIVERY OF NADIFLOXACIN USING LIPOSOMES
AHARSHIKHA SHINY, MANI CHARAN TOOMU, RAJESHRI KASHINATH DHURKE*
St. Peter's Institute of Pharmaceutical Sciences, Vidyanagar Hanamkonda, Warangal Telangana State
Email: rajeshri.dhurke@gmail.com
Received: 26 Jul 2016, Revised and Accepted: 12 Sep 2016
ABSTRACT
Objective: The objective of the research work was to develop liposomal gel of nadifloxacin in order to achieve better permeation and high drug retention into the deeper layers of the skin for effective treatment of acne vulgaris.
Methods: Various formulations were developed using different ratios of cholesterol and phospholipid (F1-F6) and evaluated for particle size distribution, shape, zeta potential, poly dispersibility index, entrapment efficiency. The best liposomal formulation was then incorporated into carbopol gel base and evaluated for drug retention studies, in vitro, and ex-vivo permeation rate and other parameters. Results obtained were compared with marketed product.
Results: Formulation (F1) with an equimolar ratio of lipid and cholesterol had vesicles in the size range of 2 to 6 µm, a large unilamellar structure with highest percent entrapment of 71±3.50. Formulation (F1) released 79±0.98% of the drug in 12h. Low drug retention in skin i. e 40±1.64 % was observed for marketed product whereas Liposomal formulation (F1) showed high drug retention of 80±1.45 % in skin layers. Zone of inhibition for developed liposomal gel (F1) was better was compared to marketed gel. Zeta potential was found to be-45.6 with a polydispersity index of 0.412 indicating homogeneities and stability of vesicles.
Conclusion: Developed liposomal formulation has better potential to treat acne due to high drug retention in skin layers.
Keywords: Nadifloxacin, Liposomes, Acne, Dermal delivery
© 2016 The Authors. Published by Innovare Academic Sciences Pvt Ltd. This is an open access article under the CC BY license (http://creativecommons.org/licenses/by/4.0/)
DOI: http://dx.doi.org/10.22159/ijap.2016v8i4.14315
INTRODUCTION
Acne is the common chronic skin disease affecting a high percentage of male and female population throughout the world. Acne is caused by Propionibacterium acnes and Staphylococcus aureus which is associated with inflammation and host immunological reactions [1, 2]. Although most of the conventional dosage forms like tablets, creams, gels, and ointments are available; they are failing in treating acne due to poor drug solubility and/or absorption, rapid metabolism, high fluctuation in the drug plasma variability due to food effect, less permeation through skin due to large globular size [3, 4]. To overcome these problems novel topical drug delivery system are preferable over conventional delivery systems. Novel topical drug delivery system includes liposomes and various types of liposomes such as liposomes, niosomes, ethos comes and transferosomes, microneedles, ultrasound and iontophoresis [5, 6]. Liposomes have high membrane fluidity which promotes penetration of the drug into deeper layers of the skin. Liposomes can deliver a large quantity of hydrophilic and lipophilic drugs, proteins, and macromolecules through the skin [7-9].
Nadifloxacin (NDF) is a fluoroquinolone with broad spectrum topical antibiotic [9] used in the treatment of multiple inflamed acne lesions. It shows bactericidal activity against propionibacterium acne and other gram positive and gram negative bacteria. The drug is poorly soluble in water with a log p of 2.47 [9, 10]. The liposomal system is most useful for the treatment of acne as it improves the skin attachment and consequently, enhances the accumulation of antibacterial agent in the target area [11]. The maximum amount of drug encapsulation and small vesicle size helps in maximum penetration of drug and produce sustained release effect at the site [12].
Hence the main aim of our research work was to determine the potential of liposome-based gel for dermal delivery of nadifloxacin so as to enhance penetration of the drug into the deeper layers of the skin, controlled drug release, and high retention in the skin layers.
MATERIALS AND METHODS
Materials
Nadifloxacin (NDF) was gift sample from Cipla R and D Center Mumbai, India, phospholipon 90H was gift sample from Lipoid GmbH Germany GmbH Germany, potassium dihydrogen phosphate, sodium hydroxide, ethanol, methanol, chloroform, cholesterol purchased from SD fine chemicals, Mumbai, India. Dialysis membrane (DM-70 Molecular weight cut-off 12000) and Mueller-Hinton agar were purchased from Hi-media, Mumbai, India. Staphylococcus aureus ATCC No. 6538 was purchased from National Chemical Laboratory, Pune, India. All the chemicals used were of analytical grade. Double distilled water was used throughout the studies.
Methods
Preparation of nadifloxacin liposomes
NDF loaded liposomes were prepared by thin film hydration technique. The lipid mixtures and drug were placed in the 100 ml round bottomed flask and dissolved by using chloroform: methanol. The organic solvent was evaporated by using Heidolph-Laborota 4001 rotary evaporator GmbH, Germany, connected to a single stage vacuum pump. Temperature and RPM were set at 45оC and 60 respectively. Thin film obtained was then hydrated with 10-15 ml of phosphate buffer 6.8pH for a period of 1h [13, 14].
Table 1: Composition of liposomal formulation
| Formulation | Nadifloxacin (mg) | Phospholipon 90H (µM) | Cholesterol (µM) | Methanol (ml) | Chloroform (ml) |
|---|---|---|---|---|---|
| F1 | 10 | 200 | 200 | 3 | 9 |
| F2 | 10 | 250 | 150 | 3 | 9 |
| F3 | 10 | 300 | 100 | 3 | 9 |
| F4 | 10 | 350 | 50 | 3 | 9 |
| F5 | 10 | 150 | 250 | 3 | 9 |
| F6 | 10 | 100 | 300 | 3 | 9 |
* Total 400 µM lipid mixture was used in all the preparations
Characterization of liposomal formulation
Vesicle shapes determination
The prepared liposomal formulation was placed on a slide, fixed by using cover slip and observed for liposomes using phase contrast microscope (HL-23, Coslab) under 450X magnification, magnified images of liposomes were captured.
Entrapment efficiency
Aliquots of liposomal formulations were subjected to centrifugation using cooling centrifuge (Remi Equipments Pvt. Ltd, Mumbai, India) at 2,500 rpm for about 2 h. The clear supernatant was then separated carefully to separate the unentrapped nadifloxacin and sediment was then treated with 1 ml of methanol to lyse the vesicles and diluted to 10 ml with methanol and absorbance of both solutions was observed at 292 nm. The amount of nadifloxacin in supernatant and sediment gave a total amount of nadifloxacin in 1 ml of dispersion [15-18]. The percent entrapment was calculated using the formula,

Drug content
The prepared liposomal formulations were taken in a test tube, to this 10 ml of methanol was added to lyse liposomes which could release the entrapped drug. The amount of nadifloxacin was determined by using U. V-Visible spectrophotometer (Spectro UV 2080, Double beam, Analytical Technologies, India) at 292 nm and amount present in the formulations were calculated [19, 20].
Preparation of liposomal gel
Carbopol gel 1% w/v base was prepared by dispersing 1 g of carbopol 934 in 100 ml of distilled water. Prepared liposomal formulation was incorporated into neutralized carbopol 934 gel base to get nNadifloxacin loaded liposomal gel (NDF LG) 1% w/w.
Characterization of liposomal gel
The prepared gels (F1-F6) were inspected visually for their color, appearance, and consistency [21, 22]. The pH of the gel was measured on a digital pH meter (Systronic equipment Pvt. Ltd, Ahmedabad, India) at ambient temperature. Before the measurement pH meter was standardized using, phosphate buffer 6.8 pH and triplicates were done. The rheological analysis of the liposomal gel of nadifloxacin was performed using a Brookfield viscometer DV-II+PRO (Viscolab 3000, Mumbai, India), equipped with standard spindle LV3 with spindle code 63. Viscosity was done in triplicates, and the mean value was calculated at 100 rpm [23]. Spreadability was determined by apparatus suggested by Mutimer et al. [1956] Two slides were taken; 3g of a gel was placed on one slide another glass slide was placed such that gel was sandwiched between two glass slides. The top slide was subjected to a stress of 50 g by putting weight on it. The time (in seconds) required by the gel to travel a distance of 10 cm was noted, shorter time interval indicates better spreadability [24].
In vitro diffusion study
In vitro drug, diffusion study was performed using Franz diffusion cell. Dialysis membrane was placed between receptor and donor compartments and a single dose equivalent liposomal formulation was placed on it; receptor compartment was filled with phosphate buffer pH 6.8 (15 ml). The diffusion cells were maintained at 37±0.5 °C with stirring at 600 rpm. (Remi Equipment Pvt. Ltd, Mumbai, India) At fixed time interval, 1 ml of the aliquot was taken for every 1, 2, 3, 4, 5, 6, 7, 8, 9, 10 and 12 h from receiver compartment through side tube and an aliquot was replaced with fresh medium. The samples were analyzed using U. V-Visible spectrophotometer [25, 26]. Drug flux (µg/h/cm2) at steady state was calculated by dividing the slope of the steady state portion of the line in the plot drug amount permeated per unit area of dialysis membrane verses time.
Ex vivo diffusion study
An ex vivo drug release study was performed using Franz diffusion cell. Porcine ear skin was placed between receptor and donor compartment. Liposomal suspension and gel equivalent to one dose were placed on porcine ear skin in the donor compartment whereas the receptor compartment was filled with phosphate buffer pH 6.8 (15 ml). The diffusion cells were maintained at 37±0.5 °C with stirring at 600 rpm (Remi Equipment Pvt. Ltd, Mumbai, India). At fixed time interval, 1 ml of aliquots was taken for every 1, 2, 3, 4, 5, 6, 7, 8, 9, 10, 11, 12 h from receiver compartment through side tube and an equal aliquot was replaced and analyzed [27, 28].
Estimation of drug retained in the skin layers
After completion of ex vivo studies, the skin was removed from the diffusion cells and the surface of skin specimens was washed with 1 ml of distilled water 8-10 times. The amount of drug present in the resultant solution was determined by UV-Visible spectrophotometry. Epidermis and dermis layers were separated by heat method [29, 30]. Skin specimens were placed in a sealed bag and placed in water maintained at 50 °C for 30 s. Dermis was separated by peeling after completion of 30 s. The separated skin layers were minced with a sterile surgical scalpel and placed in 10 ml methanol and vortexed for 5 min. Tissue suspensions were then centrifuged at 10,000 rpm for 15 min and the supernatant was filtered. Filtered supernatant tissue suspension was again extracted with methanol and filtered. The filtrate was analyzed by UV-Visible spectrophotometry.
Stability study
The prepared liposomal formulations were stored at room temperature (27±5 °C) and refrigeration (2-8 °C) for a period of 3 mo, and then visually observed for clearance of every month.
Evaluation of antibacterial activity
Antimicrobial activity for NDF in the optimized formulation i. e NDF-LG, placebo gel, and the marketed product was evaluated against Staphylococcus aureus ATCC No. 6538 by using cup plate method. Mueller-Hinton agar plates were prepared by pouring 10-15 ml of the medium into each sterile petri dish and were allowed to set at room temperature. The final concentration of micro-organisms in the inoculums was adjusted to108cfu/ml and inoculated in the agar medium using a sterile inoculation loop. Sterile borer was used to form cups in each plate. Sample equivalent to 0.2% w/w NDF was quantitatively transferred to these plates. Positive control and negative control plates were also maintained to confirm the results. The Petri plates were then incubated in the anaerobic jar at 37 °C for 48 h. After incubation zones with complete inhibition were measured and diameters of the same recorded with the help of a measuring scale. Mean zone of inhibition was recorded for all the test samples and statistically analyzed using one-way ANOVA followed by Bonferroni’s multiple comparison tests at (*P<0.05) significance level [8, 9].
Determination of particle size and zeta potential
The mean size and size distribution of Formulation F1 was determined by photon correlation spectroscopy using Zetasizer Nano ZS (Malvern Instruments CO, UK). The samples were diluted to a suitable concentration with filtered double distilled water. Size analysis was performed at 25 °C with an angle of detection of 90 °C. Size, polydispersity index was obtained directly from the instrument [31, 32].
Statistical analysis
The statistical analysis was performed using One-way analysis of variance (ANOVA) using Graph Pad prism software (Graph Pad Prism version 7.0.0.159, USA). One-way ANOVA followed by Bonferroni’s multiple comparison tests was applied for determining the statistically significant difference in antibacterial activity between various formulations. The values obtained for formulations at a P value of 0.05 was considered to be statistically significant. The characterization data were expressed as the means of three experiments±SD [31, 32].
RESULTS AND DISCUSSION
Characterization of liposomes
Vesicle shapes determination
From fig. 1 it is evident that the shape of liposomal (F1-F6) formulations was uniform and spherical showing multilamellar, onion peel structure to large and small unilamellar vesicles. The shape and size of the vesicles were dependent on the ratio of phospholipid and cholesterol used in the formulation.
Liposomal formulation (F2) containing 250 µM of phospholipon 90H and 150 µM of cholesterol showed multilamellar vesicles (MLV) with many liposomal vesicles. While formulation F5, MLV with onion peel structure is observed with reverse concentrations with the equimolar concentration of phospholipon 90H and 150 µM of cholesterol large unilamellar vesicles (LUV) were observed for formulation F1. Liposomes obtained for formulation F6 were medium sized, whereas formulation F4 showed large unilamellar vesicles (LUV), liposomal vesicles are denoted by an arrow in the respective figures.
Vesicle size is of great importance in the case of vesicular systems. The concentration of cholesterol might have influenced the size of vesicles. In this investigation, we could notice that F1 formulation with an equimolar ratio of lipid and cholesterol had a small size. The mean size of vesicles was in the range of 4 to 10 µm; it can also be noted that increasing cholesterol content subsequently decreased mean vesicle size and this may be due to increasing in the hydrophobicity of bilayers which limits the water intake to the vesicles core [31, 32].

Fig. 1: Phase contrast optical images of various liposomal formulations at 450 X magnification
Entrapment efficiency
The entrapment efficiency of all the formulations was determined using UV-Visible spectrophotometer at a wavelength of 292 nm. Formulation (F1) showed highest percent entrapment of drug i. e 71±3.50% as compared to other formulation F2, F3, F4, F5 and F6 that showed 61±3.12%, 60±2.35%, 57±0.56%, 52±0.56% and 47±0.98% respectively.
The concentration of cholesterol and phospholipid has a great influence on entrapment efficiency Formulation F1 consisting of an equimolar concentration of cholesterol and phospholipid showed high entrapment efficiency. Phospholipid is an important component for bilayer formation while cholesterol increases the bilayer hydrophobicity as well as improves the stability of liposomes. Reduced permeability of the bilayer, leads to the effective entrapment of hydrophobic drug within the hydrophobic core of the bilayer. However, formulation F5 and F6 showed low entrapment in spite of high concentration of cholesterol used as this formulation had very low concentration of phospholipid. It can be explained in a way that packing space available in the bilayer is limited and due to higher amounts of cholesterol present in those formulations might have occupied the entire space leaving less scope for entrapment of drug [31-35].
Drug content
The drug content of all developed liposomal formulations was within the limits. No signs of drug degradation were observed when the dispersion of liposomes was incorporated in carbopol gel base.
Characterization of liposomal gel
There was no significant difference found between the viscosities of all six formulations it was in the range of 27,124±3.1-31,768±0.76. The pH of the liposomal gel was in the acceptable range of 5.5-6.3 which were compatible for dermatological use. All developed formulations had good spreadability as the time taken by the slide to travel a distance of 10 cm was less than one min as compared to marketed cream. The spreadability of the developed formulation may have improved because of carbopol which results in the loose matrix of gel compared to the cream base.
In vitro diffusion study
Among the different liposomal formulations, F1 showed 72.32% drug release at the end of 12h of diffusion (fig. 2). Consequently, diffusion was higher for F1 formulation as compared to F2, F3, F4, F5, F6 and marketed formulations which showed drug release of 59.38±0.64, 56.25±1.29, 53.21±1.79, 51.15±1, 53.88±1.64, and 39.03±2.50 respectively. It is evident from the data that there is enhanced diffusion rate for liposomal formulations than conventional marketed cream. Calculated flux for F1 formulation was 5.21±0.81µg/h/cm2, while that of marketed product was 2.85±0.85 µg/h/cm2. On the basis of this data F1 formulation containing an equimolar ratio of phospholipon 90H and cholesterol was selected for further studies. The enhanced diffusion rate for liposomal formulation would be due to the vesicle size. Narrow vesicle size range results in improved diffusion through the membrane. Conventional creams have larger droplet size which restricts the permeation of drug through the membrane [9].
Ex vivo diffusion study
From the studies (fig. 3) it was observed that after 12 h percentage drug release for F1 (liposomal dispersion), F1 (liposomal gel) and marketed formulation were found to be 77.58±1.3%, 66.98±1.5, and 39.03±0.89% respectively. F1 liposomal gel showed the better-controlled release of drug as compared to marketed product. [33]. This can be explained in a similar way as that of in vitro diffusion studies, the vesicle size obtained for liposomal formulation was in the range of 4-6 µm which helps penetration of the drug into deeper layers of skin. The hydrophilic nature of liposomal gel also enhances hydration of skin which improves further permeation by hydrating stratum corneum and increasing uptake of nadifloxacin. Marketed cream on the other hand results in decrease permeation of drug due to large droplet size which fails to penetrate through stratum corneum and remains more on the surface of skin [9].

Fig. 2: In vitro diffusion studies of developed liposomal gels and marketed product

Fig. 3: Ex-vivo diffusion studies
Estimation of drug retained in the skin layers
From fig. 4 it is observed that formulation F1 (liposomal gel) showed high retention of drug in skin layers such as dermis and epidermis (81.31 %) and very low amount of drug was diffused through the skin which would lead to systemic circulation (approximately 19.03%). Marketed product, on the other hand, showed only 40.07% of drug retention in skin layers because of it large droplet size which is usually in the range of 10-100 µm. From the results, it can be concluded that liposome as a carrier not only act as a penetration enhancer for NDF but also promotes high localization of drug within the skin due to its small vesicle size [32, 33].

Fig. 4: Drug retention in skin layers
Stability studies
The stability data suggests that formulations stored at ambient temperature (i.e. room temperature) showed the signs of instability either due to phase separation or increment in particle size or presence of crystals. Formulations stored at refrigeration conditions (at 2-8 °C) sedimentation was observed which upon re-dispersion resulted in translucent to off-white solutions. Indicating that the storage of liposomes at refrigeration conditions was more preferable compared to room temperature but at the cost of increment in the particle size which suggests the instability of liposomes in aqueous dispersions and further suggests that the liposomes should be freeze dried in order to prevent the instability problems and to retain its characteristics [33, 34].
Antibacterial activity
Cup plate method depends on the principle of diffusion of antibiotic from the bore through the solidified agar preventing the growth of the microorganism in the form of the zone around the circle in which antibiotic, or sample is placed. Data obtained for antimicrobial activity is shown in fig. 5. Zone of inhibition for NDF-LG (F1 formulation) was high as compared to marketed product. A number of colonies seen throughout the Petri plate is less whereas in marketed product colonies formed are dense. Such enhanced in vitro antibacterial activity of NDF LG may be attributed due to enhanced penetration or diffusion of liposome from the gel base throughout the media. The one-way ANOVA followed by Bonferroni’s multiple comparison tests shows that formulation F1 ie. Nadifloxacin liposomal gel showed statistically significant antibacterial activity at (*P<0.05) significant level compared to conventional marketed product [9].
Determination of particle size and zeta potential
The average particle size of the F1 formulation was found to be 4-6 µm with a polydispersity index of 0.412 and zeta potential of-45.6. Low polydispersity index indicates homogeneity of vesicles. Zeta potential is a key factor signifying stability of liposomal dispersions. The magnitude of zeta potential represents the degree of electrostatic repulsion between particles that prevents particle aggregation or fusion. If the zeta potential value is above-30mV the dispersion is considered to be stable since the electric repulsion between the particles is high [32-34]. The value obtained for zeta potential was sufficient enough to control the stability of developed liposomal formulation. Negative charge obtained on the surface of vesicles may be probably due to the neutral charge on the phospholipids used and the aqueous hydration medium.
Fig. 5: Zone of inhibition of different samples, A = Marketed product B = F1 Nadifloxacin loaded liposomal gel, C = Negative control, D = Placebo gel

Fig. 6: Particle size distribution and zeta potential
CONCLUSION
Nadifloxacin loaded liposomal gels were successfully formulated using various ratios of phospholipon 90 H and cholesterol. Formulation F1 gave vesicles with desired particle size of 4-6 µm which is required for better penetration in deeper layers of skin. Low poly dispersibility index and Zeta potential of-45.6 showed good homogeneity and stability of developed liposomes. Drug loaded liposomal gel(F1) containing 1:1 ratio of phospholipid and cholesterol showed high entrapment efficiency, better penetration and high drug retention in skin layers as compared to marketed product. From the data obtained from research work, it can be concluded that liposomes as a carrier have good potential to treat chronic skin diseases effectively as compared to conventional dosage forms.
ACKNOWLEDGEMENT
Authors thanks, Cipla R and D Center, Mumbai, India for generous gift sample of nadifloxacin. Authors are thankful to Lipoid GmbH Germany for providing gift samples of phospholipon 90H.
CONFLICT OF INTERESTS
The authors declare no conflict of interest
REFERENCES
- Jappe U. Pathological mechanisms of acne with special emphasis on propionibacterium acnes and related therapy. Acta Derm Venereol 2003;83:241–8.
- Date AA, Nagarsenker MS. Design and evaluation of self-nano emulsifying drug delivery systems (SNEDDS) for cefpodoxime proxetil. Int J Pharm 2007;329:166–72.
- Surver C, Davis FA. Bioavailability and bioequivalence. In: KA Walter. eds. Dermatological and Transdermal Formulations, Marcel Dekker, New York; 2002. p. 323-7.
- Mehnert W, Mader K. Solid lipid nanoparticles: production characterization and applications. Adv Drug Delivery Rev 2001;47:165-6.
- Yasam VR, Jakki SL, Jawahar N, Gowthamarajan K. A review on novel vesicular drug delivery: proniosomes. Drug Delivery Early 2014;21;243-9.
- Gannu PK, Pogaku R. Nonionic surfactant vesicular systems for the effective drug delivery a review. Acta Pharm Sin B 2011;1:208-19.
- Hanan M, Laithy EI, Omar S, Laila G. Novel sugar esters proteasomes for transdermal delivery of vinpocetine: preclinical and clinical studies. Eur J Pharm Biopharm 2011;77:43-55.
- Ogiso T, Ninaka N, Iwaki M. Mechanism for enhancement effect of lipid disperse system on percutaneous absorption. J Pharm Sci 1996;85:57-64.
- Shinde U, Pokharkar S, Madani S. Design and evaluation of microemulsion gel system of nadifloxacin. Indian J Pharm Sci 2012;74:237-7.
- Cheng Y, Qu H, Ma M, Xu Z, Xu P, Fang Y, et al. Polyamidoamine (PAMAM) dendrimers as biocompatible carriers of quinolone antimicrobials: an in vitro study. Eur J Med Chem 2007;42:1032–8.
- Choi SY, Oh SG, Bae SY, Moon SK. Effect of short-chain alcohols as co-surfactants on pseudo-ternary phase diagrams containing lecithin. Korean J Chem Eng 1999;16:377-81.
- Sunsen VH, Vedesdal R, Kristensen HG, Christrup L, Mullertz A. Effect of liquid volume and food intake on the absolute bioavailability of danazol, a poorly soluble drug. Eur J Pharm Sci 2005;24:2987-303.
- Bernsdorff A, Wolff R, Winter EG. Effect of hydrostatic pressure on water penetration and rotational dynamics in phospholipid–cholesterol bilayers. Biophys J 1997;72:1264–77.
- Williams AC, Barry BW. Skin delivery from ultra deformable liposomes: refinement of surfactant concentration. J Pharm Pharmacol 1999;51:1123-34.
- Pokharkar VB, Padamwar MN. Development of vitamin loaded topical liposomal formulation using factorial design approach: drug deposition and stability. Int J Pharm 2006;320:37-44.
- Mourtas S, Fotopoulou S, Duraj S, Sfika V, Tsakiroglou C, Antimisiaris SG. Liposomal drugs dispersed in hydrogels effect of the liposome, drug and gel properties on drug release kinetics. Colloids Surf B 2007;55:212-21.
- Laouini A, Jaafar MC, Sfar S, Charcosset C, Fessi H. Liposome preparation using a hollow fiber membrane contactor-application to spironolactone encapsulation. Int J Pharm 2011;415:53-61.
- Ahad A, Aqil M, Kohli K, Sultana Y, Mujeeb M. Formulation and optimization of nano transfersomes using experimental design technique for accentuated transdermal delivery of valsartan. Nanomed: Nanotechnol Biol Med 2012;8:237-49.
- Seth AK, Misra A, Umrigar D. Topical liposomal gel of idoxuridine for the treatment of herpes simplex: pharmaceutical and clinical implications. Pharm Dev Technol 2004;9:277-89.
- Kumar A, Agarwal SP, Ahuja A, Ali J, Choudhari R, Baboot S. Preparation and characterization and in vitro antimicrobial assessment of nanocarrier-based formulation of nadifloxacin for acne treatment. Int J Pharm Sci 2011;66:111-4.
- Cevc G, Blume G. Lipid vesicles penetrate into intact skin owing to the transdermal osmotic gradients and hydration force. Biochim Biophys Acta 1992;1104:226-32.
- Kim MK, Chung SJ, Lee MH, Shim CK. Delivery of hydrocortisone from liposomal suspensions to the hairless mouse skin following topical application under non-occlusive and occlusive conditions. J Microencapsul 1998;15:21-9.
- Mutimer MN, Riffkin C, Hill JA, Glickman ME, Cyr GN. Modern ointment bases technology–II–comparative evaluation of bases. J Am Pharm Assoc 1956;XLV:212–8.
- Lasch J, Laub R, Wohlrab W. How deep do intact liposomes penetrate into the human skin? J Controlled Release 1991;18:55-8.
- Nina DC, Sven W, Mirjana S, Jela M, Danina K, Burkhard G, et al. Temoporfin-loaded liposomal gels: viscoelastic properties and in vitro skin penetration. Int J Pharm 2009;373:77-84.
- Subhash C, Pandey VP. Formulation and evaluation of glimepiride-loaded liposomes by ethanol injection method. Asian J Pharm Clin Res 2016;9:192-5.
- Baden HP, Gifford AM. Isometric contraction of epidermis and stratum corneum with heating. J Invest Dermatol 1970;54:298-303.
- Wester RC, Christoffel J, Hartway T, Poblete N, Maibach HI, Forsell J. Human cadaver skin viability for in vitro percutaneous absorption: storage and detrimental effects of heat-separation and freezing. Pharm Res 1998;15:82-4.
- Goindi S, Aggarwal N. Preparation of hydrogels of griseofulvin for dermal application. Int J Pharm 2006;326:20-4.
- Perrett S, Golding M, Williams WP. A simple method for the preparation of liposomes for pharmaceutical application and characterization of liposomes. J Pharm Pharmacol 1991;43:154-61.
- Parney S, Dhurke R. Effect of natural penetration enhancers on the dermal delivery of hydrocortisone acetate. J Pharm Invest 2014;44:365–80.
- Subhaschandra MP, Pandey VP. Formulation and evaluation of glimepiride-loaded liposomes by ethanol injection method. Asian J Pharm Clin Res 2016;9:192-5.
- Dubey V, Mishra D, Datta T, Nahar M, Saraf DK, Jain NK. Dermal and transdermal delivery of an anti-psoriatic agent via ethanolic liposomes. J Controlled Release 2007;123:148–54.
- Ahmed A, Rowshan A, Sengupta R. Formulation and in vitro/ex vivo characterization of microemulsion based hydrogel formulation of aceclofenac for topical application. Asian J Pharm Clin Res 2016;9:87-91.
How to cite this article
- Manicharan Toomu, Rajeshri Kashinath Dhurke. Enhanced dermal delivery of nadifloxacin using liposomes. Int J Appl Pharm 2016;8(4):53-59.